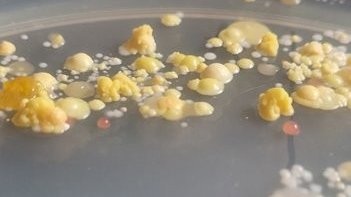

Einführung in die Welt der Mikroorganismen
- Patricia Ley
- 3 Teile | 28 Min. insgesamt
- MFA
- Teilnahmebescheinigung
In dieser 3-teiligen Videoreihe dreht sich alles um die Welt der Mikroorganismen im Wundbezug. Patricia Ley nimmt Sie mit in die Grundlagen der Mikrobiologie und erklärt anschaulich, welche Mikroorganismen eine Rolle spielen und worin sich Bakterien, Bakteriensporen und Pilze unterscheiden. Sie erfahren, warum die Eigenschaften dieser Mikroorganismen für die Wundbeurteilung so wichtig sind und wie Laborbefunde richtig eingeordnet werden. Abschließend zeigt Patricia Ley, wie dieses Wissen dabei hilft, fundierte Diagnose- und Therapieentscheidungen zu unterstützen. Viel Spaß beim Anschauen!
Downloads
Auch interessant
- Aufgezeichnetes Online-Seminar: Risiko Sepsis – Wenn jede Sekunde zählt
- Aufgezeichnetes Online-Seminar: MRSA im ambulanten Bereich – Hygiene-, Therapie- und Abrechnungsmöglichkeiten
- Antiseptika in der Wundversorgung
- Wundreinigung in der Praxis: Débridement-Methoden und Fallbeispiele
- Keime in der Wundheilung